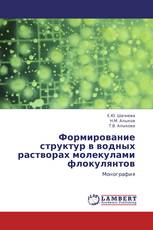
Формирование структур в водных растворах молекулами флокулянтов

Nomadic societies' culture towards formal education
Importance of knowing culture of the person before integrate with his or her society
Sifaely Muday - ISBN: 978-3-8484-4543-1
Qualitative Research In Education
Concept, Methods, Data analysis, Report Writing
Ganpatsinh S Patel - ISBN: 978-3-8473-1724-1
Non-Invasive Hyperthermia System for Brain Tumors
FDTD Based Analysis
Sulafa Yacoub, Noha Hassan - ISBN: 978-3-659-19824-3
Study Of Solid Waste Management In Different Income Group Of Lucknow
municipal solid waste and status of society in lucknow city
Shalini Chaudhary, Satya ram Chaudhary - ISBN: 978-3-659-14490-5
Формирование структур в водных растворах молекулами флокулянтов
Монография
Е.Ю. Шачнева, Н.М. Алыков, Т.В. Алыкова - ISBN: 978-3-659-20655-9
A Prospective Computed Tomographic Study
To Correlate Condylar Morpholgy with Dento-Skeletal features in Class II Malocclusion
Mohd Toseef Khan, Sanjeev Kumar Verma, Sandhya Maheshwari - ISBN: 978-3-659-20421-0
Attitudinal & Behavioral Outcomes Link with Employee Development
In the Context of Performance Appraisal: Empirical Evidence from the Public Universities of Khyber Pakhtunkhwa, Pakistan
Wali Rahman - ISBN: 978-3-659-20687-0
К образованному миру
Представления о пространстве и времени в картине мира декабристов
Светлана Вольф - ISBN: 978-3-659-18664-6
Коммуникативные стратегии и тактики американцев и россиян
гендерный аспект
Татьяна Гацура - ISBN: 978-3-8484-1334-8